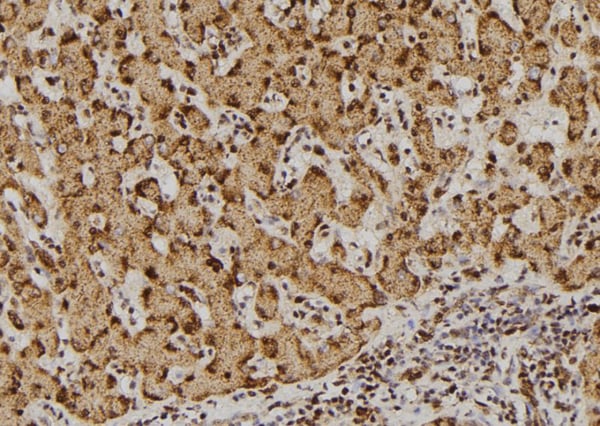
product-image-AAA321983_IHC15.jpg

Rabbit DDX3/DEAD box Protein 3 Polyclonal Antibody | anti-DDX3X antibody
DDX3/DEAD box Protein 3 Antibody
Phosphate buffered saline, pH 7.4, 150mM NaCl, 0.02% sodium azide and 50% glycerol.
IF (Immunofluorescence)
(AAA321983 staining HeLa cells by IF/ICC. The sample were fixed with PFA and permeabilized in 0.1% Triton X-100, then blocked in 10% serum for 45 minutes at 25 degree C. The primary antibody was diluted at 1/200 and incubated with the sample for 1 hour at 37 degree C. An Alexa Fluor 594 conjugated goat anti-rabbit IgG (H+L) antibody, diluted at 1/600, was used as secondary antibody.)
IHC (Immunohistochemistry)
(AAA321983 at 1/100 staining Human liver tissue by IHC-P. The sample was formaldehyde fixed and a heat mediated antigen retrieval step in citrate buffer was performed. The sample was then blocked and incubated with the antibody for 1.5 hours at 22 degree C. An HRP conjugated goat anti-rabbit antibody was used as the secondary.)
Function: Multifunctional ATP-dependent RNA helicase. The ATPase activity can be stimulated by various ribo-and deoxynucleic acids indicative for a relaxed substrate specificity. In vitro can unwind partially double-stranded DNA with a preference for 5'-single-stranded DNA overhangs. Is involved in several steps of gene expression, such as transcription, mRNA maturation, mRNA export and translation. However, the exact mechanisms are not known and some functions may be specific for a subset of mRNAs. Involved in transcriptional regulation. Can enhance transcription from the CDKN1A/WAF1 promoter in a SP1-dependent manner. Found associated with the E-cadherin promoter and can down-regulate transcription from the promoter. Involved in regulation of translation initiation. Proposed to be involved in positive regulation of translation such as of cyclin E1/CCNE1 mRNA and specifically of mRNAs containing complex secondary structures in their 5'UTRs; these functions seem to require RNA helicase activity. Specifically promotes translation of a subset of viral and cellular mRNAs carrying a 5'proximal stem-loop structure in their 5'UTRs and cooperates with the eIF4F complex. Proposed to act prior to 43S ribosomal scanning and to locally destabilize these RNA structures to allow recognition of the mRNA cap or loading onto the 40S subunit. After association with 40S ribosomal subunits seems to be involved in the functional assembly of 80S ribosomes; the function seems to cover translation of mRNAs with structured and non-structured 5'UTRs and is independent of RNA helicase activity. Also proposed to inhibit cap-dependent translation by competetive interaction with EIF4E which can block the EIF4E:EIF4G complex formation. Proposed to be involved in stress response and stress granule assembly; the function is independent of RNA helicase activity and seems to involve association with EIF4E. May be involved in nuclear export of specific mRNAs but not in bulk mRNA export via interactions with XPO1 and NXF1. Also associates with polyadenylated mRNAs independently of NXF1. Associates with spliced mRNAs in an exon junction complex (EJC)-dependent manner and seems not to be directly involved in splicing. May be involved in nuclear mRNA export by association with DDX5 and regulating its nuclear location. Involved in innate immune signaling promoting the production of type I interferon (IFN-alpha and IFN-beta); proposed to act as viral RNA sensor, signaling intermediate and transcriptional coactivator. Involved in TBK1 and IKBKE-dependent IRF3 activation leading to IFNB induction, plays a role of scaffolding adapter that links IKBKE and IRF3 and coordinates their activation. Also found associated with IFNB promoters; the function is independent of IRF3. Can bind to viral RNAs and via association with MAVS/IPS1 and DDX58/RIG-I is thought to induce signaling in early stages of infection. Involved in regulation of apoptosis. May be required for activation of the intrinsic but inhibit activation of the extrinsic apoptotic pathway. Acts as an antiapoptotic protein through association with GSK3A/B and BIRC2 in an apoptosis antagonizing signaling complex; activation of death receptors promotes caspase-dependent cleavage of BIRC2 and DDX3X and relieves the inhibition. May be involved in mitotic chromosome segregation. Is an allosteric activator of CSNK1E, it stimulates CSNK1E-mediated phosphorylation of DVL2 and is involved in the positive regulation of canonical Wnt signaling (PubMed:23413191).
Subunit Structure: Binds RNA as a monomer at low DDX3X concentrations and as a dimer at high DDX3X concentrations (PubMed:27546789). Interacts with XPO1, TDRD3, PABPC1, NXF1, EIF3C, MAVS, DDX58 and NCAPH (PubMed:15507209, PubMed:18632687, PubMed:18596238, PubMed:20127681, PubMed:21170385, PubMed:21730191, PubMed:21883093, PubMed:22323517, PubMed:22872150). Interacts with DDX5; the interaction is regulated by the phosphorylation status of both proteins (PubMed:22034099). Interacts with EIF4E; DDX3X competes with EIF4G1/EIF4G3 for interaction with EIF4E (PubMed:17667941, PubMed:21883093). Interacts with IKBKE; the interaction is direct, found to be induced upon virus infection (PubMed:20375222, PubMed:20657822, PubMed:23478265). Interacts (when phosphorylated at Ser-102) with IRF3; the interaction allows the phosphorylation and activation of IRF3 by IKBKE (PubMed:23478265). Interacts with TBK1 (PubMed:20375222). Associates with the eukaryotic translation initiation factor 3 (eIF-3) complex (PubMed:18628297). Associates with the 40S ribosome (PubMed:22323517). Identified in a mRNP complex, at least composed of DHX9, DDX3X, ELAVL1, HNRNPU, IGF2BP1, ILF3, PABPC1, PCBP2, PTBP2, STAU1, STAU2, SYNCRIP and YBX1 (PubMed:19029303). Interacts with SP1 (PubMed:16818630). Interacts with GSK3A, GSK3B and TNFRSF10B (PubMed:18846110). Interacts with HCV core protein (PubMed:10329544). Interacts with vaccinia virus (VACV) protein K7 (PubMed:18636090, PubMed:19913487). Found in a complex with HIV-1 Rev and XPO1 (PubMed:15507209). Interacts with CSNK1E; the interaction enhances CSNK1E recruitement to DVL2 (PubMed:23413191). Interacts with DHX33; the interaction is independent of RNA (PubMed:26100019).
Post-translational Modifications: Phosphorylated by TBK1; the phosphorylation is required to synergize with TBK1 in IFNB induction. Phosphorylated by IKBKE at Ser-102 after ssRNA viral infection; enhances the induction of INFB promoter by IRF3. The cytoplasmic form is highly phosphorylated in the G1/S phase and much lower phosphorylated in G2/M.
Similarity: Belongs to the DEAD box helicase family. DDX3/DED1 subfamily.
NCBI and Uniprot Product Information
Predicted: 74 kDa
Customer Reviews
Loading reviews...
Share Your Experience
Similar Products
Product Notes
The DDX3X ddx3x (Catalog #AAA321983) is an Antibody produced from Rabbit and is intended for research purposes only. The product is available for immediate purchase. The DDX3/DEAD box Protein 3 Antibody reacts with Human, Mouse, Rat and may cross-react with other species as described in the data sheet. AAA Biotech's DDX3/DEAD box Protein 3 can be used in a range of immunoassay formats including, but not limited to, ELISA, ICC (Immunocytochemistry), IF (Immunofluorescence), IHC (Immunohistochemistry), WB (Western Blot). Researchers should empirically determine the suitability of the DDX3X ddx3x for an application not listed in the data sheet. Researchers commonly develop new applications and it is an integral, important part of the investigative research process. It is sometimes possible for the material contained within the vial of "DDX3/DEAD box Protein 3, Polyclonal Antibody" to become dispersed throughout the inside of the vial, particularly around the seal of said vial, during shipment and storage. We always suggest centrifuging these vials to consolidate all of the liquid away from the lid and to the bottom of the vial prior to opening. Please be advised that certain products may require dry ice for shipping and that, if this is the case, an additional dry ice fee may also be required.Precautions
All products in the AAA Biotech catalog are strictly for research-use only, and are absolutely not suitable for use in any sort of medical, therapeutic, prophylactic, in-vivo, or diagnostic capacity. By purchasing a product from AAA Biotech, you are explicitly certifying that said products will be properly tested and used in line with industry standard. AAA Biotech and its authorized distribution partners reserve the right to refuse to fulfill any order if we have any indication that a purchaser may be intending to use a product outside of our accepted criteria.Disclaimer
Though we do strive to guarantee the information represented in this datasheet, AAA Biotech cannot be held responsible for any oversights or imprecisions. AAA Biotech reserves the right to adjust any aspect of this datasheet at any time and without notice. It is the responsibility of the customer to inform AAA Biotech of any product performance issues observed or experienced within 30 days of receipt of said product. To see additional details on this or any of our other policies, please see our Terms & Conditions page.Item has been added to Shopping Cart
If you are ready to order, navigate to Shopping Cart and get ready to checkout.